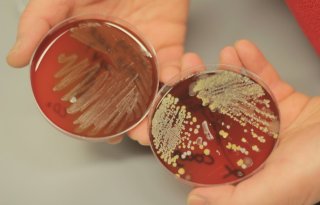
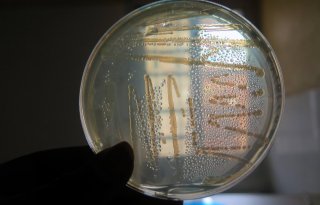

Onderzoek naar verspreiding resistente kiemen tijdens veetransport
De invloed van veetransport op de verspreiding van kiemen met een antimicrobiële resistentie wordt onderzocht door de Europese Autoriteit voor Voedselveiligheid (Efsa). Onder de loep liggen kiemen die overdraagbaar zijn van koeien, varkens en pluimvee op de mens en kunnen zorgen voor een lastig te behandelen zoönose.
Het onderzoeksproject is aangevraagd door de Commissie milieubeheer, volksgezondheid en voedselveiligheid van het Europees Parlement. Het richt zich op het risico van verspreiding van resistente zoönotische bacteriën onder pluimvee, varkens en runderen tijdens het transport naar andere boerderijen of slachthuizen.
Het gaat bij dit onderzoek om de verspreiding van resistente kiemen die een zoönose kunnen veroorzaken, een van dier op mens overdraagbare aandoening. Als zo'n overgedragen kiem resistent is tegen specifieke antibiotica kan dat de behandeling van geïnfecteerde mensen lastig maken.
Wetenschappelijk advies
Naast het onderzoeken van de factoren die de verspreiding van antimicrobiële resistente bacteriën via transport kunnen veroorzaken, beoordeelt Efsa ook preventieve maatregelen en controle-opties. Het definitieve wetenschappelijke advies wordt naar verwachting in september 2022 afgerond.
Volgens Efsa-hoofdwetenschapper Marta Hugas is resistentie tegen antimicrobiële stoffen een dringende bedreiging voor de volksgezondheid. 'Wetenschappelijk onderbouwd advies is van cruciaal belang voor het ontwikkelen van beleid en wetgeving om deze uitdaging aan te gaan.'
One-health-benadering
Het nieuwe project, dat zich richt op de mogelijke consequenties voor de menselijke gezondheid, illustreert volgens Hugas de noodzaak van een One Health-benadering door beoordelaars en beleidsmakers. Bij een One Health-aanpak wordt er vanuit meerdere disciplines samengewerkt om de gezondheid van mensen, dieren en milieu te verbeteren.
Bekijk meer over:
Lees ook
Meest gelezen
Blogs




Bedrijf in Beeld
Partners
Stelling
Nieuws van NieuweOogst.nl